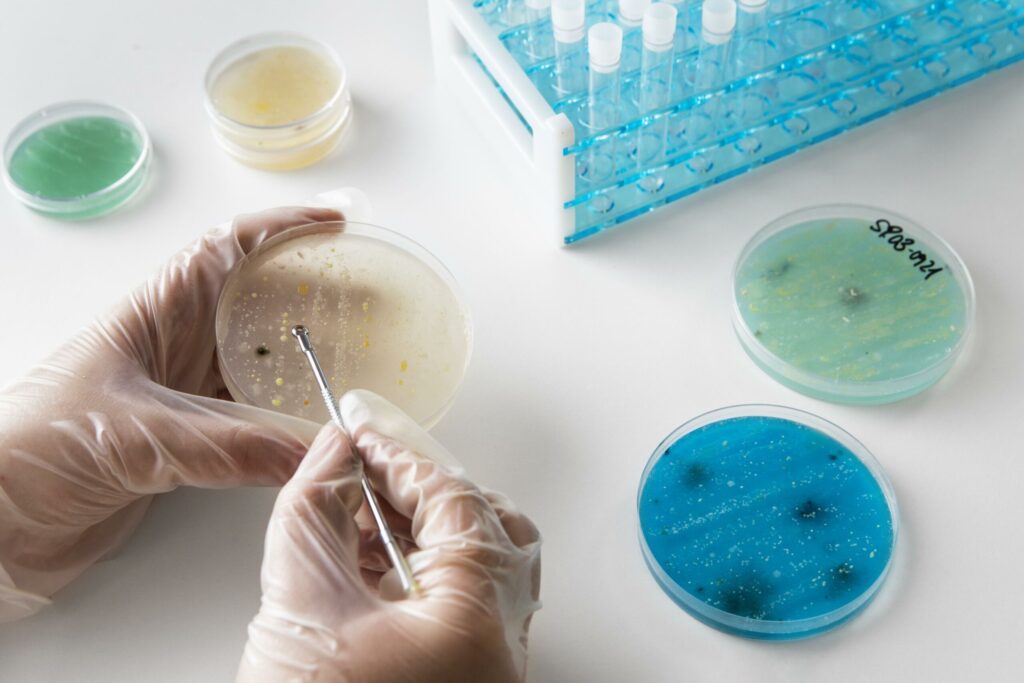

Um fungo mortal, capaz de infectar milhões de pessoas por ano, pode se espalhar por novas regiões da Europa, Ásia e América devido ao aumento das temperaturas causado pelas mudanças climáticas, segundo um estudo da Universidade de Manchester, na Inglaterra.
O Aspergillus fumigatus, que pode provocar infecções pulmonares, cerebrais e até tornar plantações impróprias para consumo, está no centro das preocupações de cientistas, que alertam para o risco de uma crise de saúde pública.
O fungo, que prospera em temperaturas elevadas, pode expandir sua presença em até 77% do território europeu até 2100, caso o uso intenso de combustíveis fósseis continue. Isso poderia expor cerca de nove milhões de pessoas na Europa à infecção, segundo o jornal britânico The Independent.
Outra espécie de fungo, o Aspergillus flavus, pode se espalhar por 16% do território no norte da China, Rússia, Escandinávia e Alasca, além de tornar áreas no Brasil e em países africanos inóspitas para sua sobrevivência, afetando ecossistemas locais.
“Estamos falando de centenas de milhares de vidas e mudanças continentais na distribuição de espécies. Em 50 anos, onde as coisas crescem e o que te infecta será completamente diferente”, disse Norman van Rhijn, principal autor do estudo, ao jornal britânico Financial Times.
Van Rhijn também disse ao canal de notícias britânico Sky News que as infecções causadas por fungos são “extremamente difíceis” de tratar devido à escassez de medicamentos antifúngicos e à crescente resistência desses organismos aos tratamentos disponíveis.
Riscos para saúde e alimentação
A aspergilose, doença pulmonar causada pelos esporos do Aspergillus, é uma das principais ameaças. Esses esporos, presentes no ar, podem se espalhar para outros órgãos, e são especialmente perigosos para pessoas com asma, fibrose cística ou sistemas imunológicos debilitados.
Além dos riscos à saúde humana, o fungo também ameaça a segurança alimentar e a pecuária, já que pode infectar plantações e gado. “Existem sérias ameaças deste organismo tanto em termos de saúde humana quanto de segurança alimentar”, disse Darius Armstrong-James, professor de doenças infecciosas no Imperial College London, ao Financial Times.
O estudo aponta que a extensão da disseminação do fungo dependerá da velocidade com que o mundo reduzir o uso de combustíveis fósseis. Isso significa que uma ação lenta aumentará o risco para mais pessoas.
Apesar da periculosidade, o Aspergillus também tem usos benéficos, como na fermentação de molho de soja e saquê. No entanto, a capacidade de prosperar em ambientes quentes, como o corpo humano a 37°C, torna-o uma ameaça crescente.
Os cientistas também chamam a atenção para a falta de conhecimento sobre fungos. Estima-se que mais de 90% das espécies fúngicas ainda sejam desconhecidas pela ciência, o que dificulta o desenvolvimento de estratégias de prevenção e tratamento.